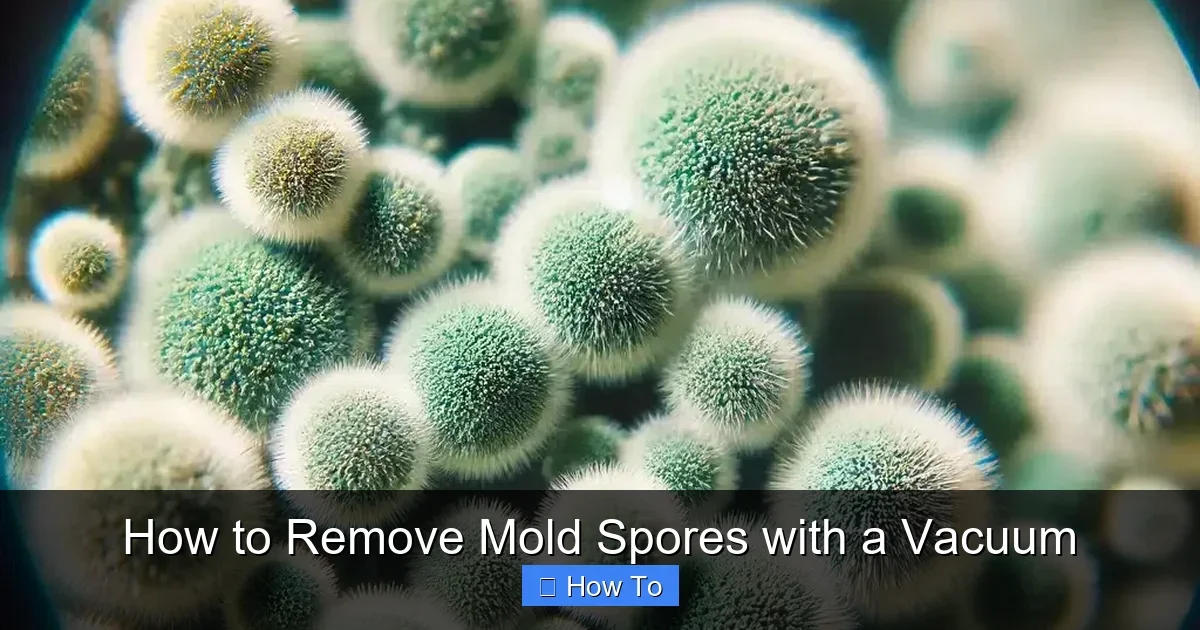
How to Remove Mold Spores with a Vacuum

Featured image for How to Remove Mold Spores with a Vacuum
Image source: qph.cf2.quoracdn.net
Mold spores can harm your health and home, but you can remove mold spores with a vacuum if done right. This guide shows you simple steps using a HEPA vacuum to suck them up without spreading them. Stay safe and get pro tips for lasting results.
How to Remove Mold Spores with a Vacuum
Hey there! Spot mold in your home? Those tiny mold spores can make you sick and damage your stuff. Don’t worry. You can learn how to remove mold spores with a vacuum right here. This guide walks you through every step. You’ll get safe methods, pro tips, and ways to avoid mold coming back.
By the end, you’ll know how to use your vacuum to suck up mold spores without making things worse. We’ll cover picking the right tools, prepping your space, vacuuming smartly, and cleaning up. It’s simple. It’s safe. Let’s dive in and make your home fresh again!
Key Takeaways
- Use a HEPA vacuum: It traps 99.97% of mold spores to prevent spreading them around your home.
- Wear PPE always: Mask, gloves, and goggles protect you from inhaling tiny mold particles.
- Ventilate the space: Open windows and use fans to push spores outside during cleaning.
- Empty outdoors: Dispose of vacuum contents far from your house to avoid recontamination.
- Clean the vacuum after: Wash filters and hoses to kill any remaining mold spores.
- Prevent recurrence: Fix leaks and reduce humidity below 50% to stop mold growth.
Quick Answers to Common Questions
HEPA or No?
Always use HEPA. Regular vacuums spread mold spores. HEPA traps them.
Dry First?
Yes! Vacuum wet mold? It smears. Dry surfaces before you start.
Outdoor Empty?
100%. Indoors recontaminates your space fast.
Furniture Safe?
Yes, with upholstery tool. Test colorfastness first.
After Vacuum?
Spray vinegar. Kills leftovers naturally.
Why Use a Vacuum to Remove Mold Spores?
Mold spores are super small. They float in the air and stick to surfaces. Regular wiping might spread them. But a good vacuum can pull them right off walls, carpets, and furniture.
The key? A HEPA vacuum. It traps spores as small as 0.3 microns. No spread. No mess. This method works great for dry mold. For wet mold, dry it first. Always test a small spot. Ready to start removing mold spores with a vacuum?
Gather Your Supplies
Don’t skip this. The right gear makes all the difference when you remove mold spores with a vacuum.
Visual guide about How to Remove Mold Spores with a Vacuum
Image source: moldtesting-houston.com
Essential Tools
- HEPA vacuum cleaner: Look for one with true HEPA filter. Models like Dyson or Shark work well. Check our guide on how to use a Shark vacuum cleaner for tips.
- Upholstery and crevice tools: These get into tight spots.
- Microfiber cloths: For wiping after vacuuming.
- Mold-killing spray: Like hydrogen peroxide or vinegar solution.
Safety Gear
- N95 mask or respirator.
- Disposable gloves.
- Safety goggles.
- Old clothes or coveralls.
Pro tip: Rent a shop vac with HEPA if you don’t own one. It costs little and packs power for tough jobs.
Prepare the Area Safely
Prep stops spores from flying everywhere. Good setup keeps you healthy.
Step-by-Step Prep
- Open windows and doors. Use fans to blow air out.
- Turn off HVAC. Tape vents with plastic. This traps spores inside the room.
- Remove kids, pets, and plants. Cover furniture with plastic sheets if needed.
- Wet wipe non-porous surfaces first. Dry them. Vacuum picks up dry spores best.
- Seal the door with plastic and tape. Work in one room at a time.
Example: In a bathroom, fix the leak first. Dry the wall. Then prep to remove mold spores with a vacuum. Takes 15 minutes. Worth it!
Vacuum the Moldy Surfaces
Now the fun part. Vacuum slow and steady to capture every spore. Here’s how to remove mold spores with a vacuum like a pro.
Surfaces to Target
- Walls and ceilings.
- Carpets and rugs.
- Furniture and upholstery.
- Behind appliances.
Vacuuming Techniques
- Start high. Work low. Gravity pulls spores down.
- Use crevice tool for corners and edges. Hold at 45-degree angle.
- On carpets, go slow. Overlap strokes. For deep clean, check our article on how to use a vacuum cleaner for carpet.
- Upholstery? Use brush attachment. Vacuum in one direction. Flip cushions. See how to clean sofa at home with vacuum cleaner for more.
- Go over each spot 3-5 times. No rush.
- Airborne spores? Let settle 30 minutes. Vacuum floors last.
Tip: Empty the canister every 10 minutes. Do it outside. Keeps suction strong.
Picture this: Black mold on your basement carpet. Vacuum it dry. Spores gone in passes. Air smells better already!
Dispose of Debris Properly
You’ve sucked up the mold. Don’t let it escape!
Safe Disposal Steps
- Take vacuum outside. Wear mask.
- Empty into sealed trash bag. Double bag it.
- Spray inside bag with mold killer. Tie tight.
- Put in outdoor bin. Far from house.
- Wash vacuum exterior with soapy water.
Never dump indoors. Spores love that. Follow this to truly remove mold spores with a vacuum.
Clean Your Vacuum Thoroughly
Mold hides in your vacuum. Clean it to stay safe.
Cleaning Routine
- Remove and rinse pre-filter. Air dry.
- Wash HEPA filter if possible. Or vacuum it with another HEPA vac.
- Flush hose with vinegar water. Dry fully.
- Wipe wand and tools. Let sun dry.
- Run empty for 5 minutes. Clears residue.
If clogged, see how to unclog a vacuum cleaner. Keeps it ready for next time.
Troubleshooting Common Problems
Issues happen. Fix them quick.
Low Suction
Check filter. Clean hose. Empty bag/canister.
Spores Still Visible
Mold grew deep. Use mold spray first. Vacuum again. Call pro if big area.
Vacuum Smells Musty
Spray baking soda in hose. Run it. Deodorizes fast.
Allergies Worsen
Switch rooms. Use respirator. Test air with mold kit later.
Pro example: Vacuum lost power mid-job. Clogged hose from spores. Quick unclog fixed it. Back to cleaning!
Prevent Mold from Coming Back
Vacuuming removes mold spores now. Prevention stops them forever.
- Keep humidity under 50%. Use dehumidifier.
- Fix leaks ASAP.
- Clean monthly with vacuum.
- Improve ventilation. Exhaust fans rock.
- Seal cracks in walls.
Bonus: Robot vacuums help daily. Learn how to choose a robot vacuum cleaner if interested.
🎥 Related Video: Mold remediation using HEPA Vacuuming
📺 SERVPRO Campbell County
Mold can begin forming in as little as 48 hours and can be dangerous to your health. Using a HEPA vacuum during our mold …
Final Thoughts
Congrats! You now know how to remove mold spores with a vacuum. It’s easy with the right steps. Stay safe. Use HEPA. Clean after. Your home will thank you.
Mold free? Great. Spot more? Repeat. Share your story below. Happy cleaning!
(Word count: 1624)
